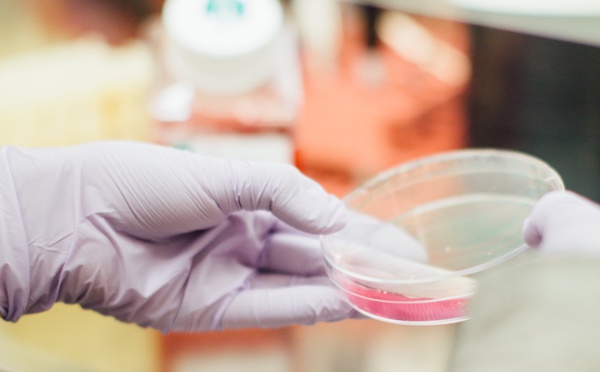

|
Applications analytiques
IA : vers un véritable gain de temps dans la gestion des notes de frais ? - Communiqué de SAP, 27/02/2019
Notes de frais : une expression qui fait presque universellement grincer des dents. Sentiments d'anxiété et de frustration, la gestion de la note de frais se révèle être une tâche fastidieuse et chronophage. Les progrès de l'IA améliorent rapidement les processus de gestion des dépenses. Et comme...
Le groupe Mind7 Consulting lance MyRTEA Metrics - Communiqué de Mind7 Consulting, 23/02/2019
Le groupe Mind7 Consulting innove sur le marché en annonçant le lancement de son activité « logiciel ». Société à part entière, MyRTEA Metrics développe et commercialise un assistant virtuel, une intelligence artificielle qui s’appuie sur les faits, les connaissances et les sentiments pour aider...
RGPD : l’opportunité pour les marques d’hyper personnaliser l’expérience client - Stéphane Amarsy, Inbox, 20/02/2019
Grâce à l’équilibre dans la relation entreprise – consommateur apporté par le RGPD, les marques ont l’opportunité de se différencier en favorisant une expérience client unique et individualisée. S’adapter à nouvel équilibre entreprise – consommateur À l’heure du digital et du volume exponentiel de...
Delair lance delair.ai, la plate-forme d’intelligence aérienne la plus complète du marché pour visualiser et exploiter les données drones - Communiqué de Delair, 15/02/2019
delair.ai crée et gére des jumeaux numériques dans le cloud, permettant aux entreprises de mieux comprendre et piloter leurs ressources stratégiques Delair conforte sa position dominante sur un marché mondial en cours de consolidation : delair.ai est le fruit de son positionnement précurseur sur le...
IBM révolutionne avec Sigfox le suivi des conteneurs au sein du Groupe PSA - Communiqué de IBM, 31/01/2019
La solution «Track&Trace » de suivi des conteneurs s’appuie sur le réseau international Sigfox et IBM Watson IoT. IBM annonce avec Sigfox le lancement au sein du Groupe PSA de la solution innovante « Track&Trace » pour la digitalisation du suivi des emballages (conteneurs) entre les fournisseurs et...
Les technologies SAS contribuent aux innovations en oncologie pour combattre le cancer - Communiqué de SAS, 28/01/2019
Avec le soutien de SAS, le LACOG* a d’ores et déjà augmenté son volume de nouvelles études de 100 % depuis l’adoption de SAS Analytics Pro en 2015. Comme d’autres organisations dans le monde, le Groupe d’oncologie coopérative d’Amérique latine (LACOG) installé à Porto Alegre (Brésil) est conscient...
Mes prédictions pour 2019 : Objets, données, mais surtout algorithmes - Philippe Nieuwbourg , 27/01/2019
Au cœur du cycle objets, données, algorithmes, les données sont un composant essentiel. Mais n’oublions pas les algorithmes, dont l’explicabilité et l’auditabilité, deviendront en 2019 un élément stratégique. Une gouvernance des données, mais également de ces algorithmes ; Et quelques regards...
Dhatim, grâce à l'Intelligence Artificielle, permet aux départements RH, SIRH, de contrôler et de sécuriser les données de paie et sociales et participe de la cohésion sociale des entreprises - Communiqué de Dhatim, 16/01/2019
L'IA confirme sa percée dans l'accompagnement des Directions RH, SIRH des entreprises. Conciliator ™ PAY, solution à base d'IA et de Machine Learning, permet d'automatiser l'analyse des données de la paie et des données sociales et s'impose comme un véritable indicateur de la digitalisation de ces...
IBM développe son nouveau système météo, IBM Weather System, améliorant considérablement les prévisions météorologiques dans le monde entier - Communiqué de IBM, 10/01/2019
IBM (NYSE : IBM) et sa filiale The Weather Company dévoilent aujourd’hui leur nouveau système de prévision météorologique, un système puissant et mondial, fournissant les prévisions climatiques les plus précises au monde, à l’échelle locale. Ce nouveau système, baptisé Global High-Resolution...
Nordic Capital annonce l’acquisition de BOARD International - Communiqué de Board, 09/01/2019
BOARD International fournit la seule solution sur le marché proposant une plateforme intégrée pour le Business Intelligence, le Pilotage de la Performance et l’Analyse Prédictive. La plateforme d’aide à la décision a permis aux entreprises partout dans le monde de piloter efficacement leurs...
|